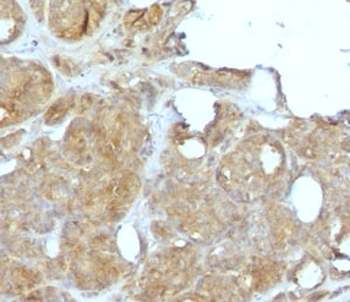
Recombinant MVP Antibody

You have no items in your shopping cart.
- Rabbit STAT1 Recombinant Monoclonal Antibody [orb1519684]
IP, WB
Human
Rabbit
Recombinant
Unconjugated
100 μl, 20 μl FC
Human
Rabbit
Monoclonal
Unconjugated
200 μl, 20 μl- Recombinant Erythropoietin Antibody / EPO [orb2643528]
IHC-P
Human
Rabbit
Recombinant
Unconjugated
100 μg